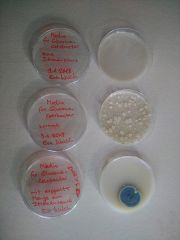

This special page shows all uploaded files.
| Date | Name | Thumbnail | Size | Description | Versions |
|---|---|---|---|---|---|
| 16:27, 24 January 2018 | ExtractedBacteria3.jpg (file) |  |
1.91 MB | File uploaded with MsUpload | 1 |
| 16:27, 24 January 2018 | ExtractedBacteria2.jpg (file) |  |
2.14 MB | File uploaded with MsUpload | 1 |
| 16:26, 24 January 2018 | ExtractedBacteria.jpg (file) |  |
3.33 MB | File uploaded with MsUpload | 1 |
| 16:15, 24 January 2018 | Ink3.jpg (file) |  |
2.08 MB | File uploaded with MsUpload | 1 |
| 16:14, 24 January 2018 | Ink2.jpg (file) |  |
3 MB | File uploaded with MsUpload | 1 |
| 16:13, 24 January 2018 | Ink.jpg (file) |  |
4.05 MB | File uploaded with MsUpload | 1 |
| 16:07, 24 January 2018 | Rot2.jpg (file) |  |
1.28 MB | File uploaded with MsUpload | 1 |
| 16:07, 24 January 2018 | Rot1.jpg (file) |  |
1.9 MB | File uploaded with MsUpload | 1 |
| 16:06, 24 January 2018 | IMG 20180124 144348.jpg (file) |  |
1.9 MB | File uploaded with MsUpload | 1 |
| 16:03, 24 January 2018 | RotePigmente.jpg (file) |  |
1.35 MB | File uploaded with MsUpload | 1 |
| 15:59, 24 January 2018 | GemalterPilz.jpg (file) |  |
4.12 MB | File uploaded with MsUpload | 1 |
| 15:58, 24 January 2018 | PilzAnmalen.jpg (file) |  |
1.87 MB | File uploaded with MsUpload | 1 |
| 15:50, 24 January 2018 | Nährböden2.jpg (file) |  |
4.27 MB | File uploaded with MsUpload | 1 |
| 15:19, 17 January 2018 | InkMedium.jpg (file) |  |
3.33 MB | File uploaded with MsUpload | 1 |
| 15:13, 17 January 2018 | IMG 20180117 141453.jpg (file) |  |
1.3 MB | File uploaded with MsUpload | 1 |
| 15:07, 17 January 2018 | Nährböden.jpg (file) | |
5.42 MB | File uploaded with MsUpload | 1 |
| 15:04, 17 January 2018 | FructoseMedium.jpg (file) |  |
1.28 MB | File uploaded with MsUpload | 1 |
| 15:03, 17 January 2018 | IMG 20180117 141640.jpg (file) |  |
1.28 MB | File uploaded with MsUpload | 1 |
| 14:59, 17 January 2018 | Fußpilz3.jpg (file) |  |
4.33 MB | File uploaded with MsUpload | 1 |
| 14:58, 17 January 2018 | Fußpilz2.jpg (file) |  |
4.33 MB | File uploaded with MsUpload | 2 |
| 18:27, 10 January 2018 | IMG 20180110 191742.jpg (file) |  |
1.4 MB | File uploaded with MsUpload | 1 |
| 16:34, 10 January 2018 | ShapeDrawing.jpg (file) |  |
1.27 MB | File uploaded with MsUpload | 1 |
| 16:31, 10 January 2018 | VerschiedeneMedien.jpg (file) |  |
1.38 MB | File uploaded with MsUpload | 2 |
| 16:18, 10 January 2018 | WaterResult.jpg (file) |  |
2 MB | File uploaded with MsUpload | 1 |
| 11:09, 16 December 2017 | MediumOnPAper.jpg (file) |  |
2.04 MB | File uploaded with MsUpload | 1 |
| 11:07, 16 December 2017 | Medium.jpg (file) |  |
1.71 MB | File uploaded with MsUpload | 1 |
| 10:57, 16 December 2017 | Atompilz-1.jpg (file) |  |
2.24 MB | File uploaded with MsUpload | 1 |
| 10:56, 16 December 2017 | Fußpilz.jpg (file) |  |
2.27 MB | File uploaded with MsUpload | 1 |